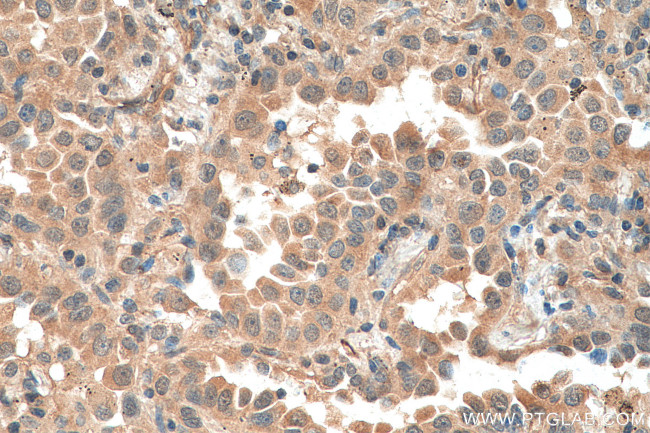
EIF5A2 Antibody in Immunohistochemistry (Paraffin) (IHC (P))

Search
Proteintech
EIF5A2 Monoclonal Antibody (1F9B2)
{{$productOrderCtrl.translations['antibody.pdp.commerceCard.promotion.promotions']}}
{{$productOrderCtrl.translations['antibody.pdp.commerceCard.promotion.viewpromo']}}
{{$productOrderCtrl.translations['antibody.pdp.commerceCard.promotion.promocode']}}: {{promo.promoCode}} {{promo.promoTitle}} {{promo.promoDescription}}. {{$productOrderCtrl.translations['antibody.pdp.commerceCard.promotion.learnmore']}}
产品信息
67907-1-IG
种属反应
宿主/亚型
分类
类型
克隆号
抗原
偶联物
形式
浓度
规格
纯化类型
保存液
内含物
保存条件
运输条件
产品详细信息
Aliquoting is unnecessary for -20°C storage.
靶标信息
mRNA-binding protein involved in translation elongation. Has an important function at the level of mRNA turnover, probably acting downstream of decapping. Involved in actin dynamics and cell cycle progression, mRNA decay and probably in a pathway involved in stress response and maintenance of cell wall integrity. Functions as a regulator of apoptosis. Mediates effects of polyamines on neuronal process extension and survival. May play an important role in brain development and function, and in skeletal muscle stem cell differentiation.
仅用于科研。不用于诊断过程。未经明确授权不得转售。
篇参考文献 (0)
生物信息学
蛋白别名: eIF-5A-2; eIF5AII; translation factor; hypusine-containing protein; eukaryotic initiation factor 5A; Eukaryotic initiation factor 5A isoform 2; Eukaryotic translation initiation factor 5A-2; unnamed protein product
基因别名: EIF-5A2; EIF5A2; eIF5AII
UniProt ID: (Human) Q9GZV4
Entrez Gene ID: (Human) 56648, (Rat) 310261